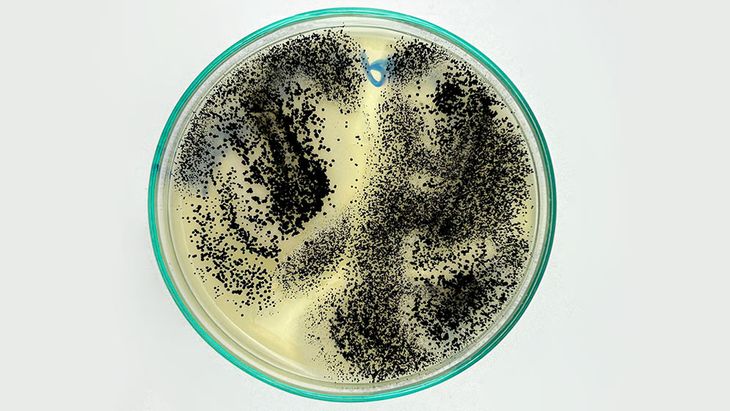
Hongo (Aspergillus sp) aislado de pasas de uva. Foto: gentileza Conicet Hongo (Aspergillus sp) aislado de pasas de uva. Foto: gentileza Conicet

Las pasas de uva de Argentina, ¿a un paso de conquistar el mundo?
Un equipo del CONICET y la Universidad de San Juan, junto a empresas locales y expertos internacionales, está desarrollando bioinsumos para eliminar hongos tóxicos en este fruto seco.
Con exportaciones récord en 2024 y un proyecto que promete reducir pérdidas y potenciar la economía de San Juan, la innovación biotecnológica que está poniendo en marcha un equipo de investigación del CONICET y la Universidad de San Juan podría cambiar el negocio de las pasas de uva.
Argentina consolidó su lugar como el octavo productor mundial de pasas de uva, exportando 43.515 toneladas en 2024, un impresionante 70% más que las 25.656 toneladas de 2023. Brasil se lleva el 59% del total, seguido por EE.UU. y Colombia.
La provincia de San Juan, corazón de esta industria, lidera la producción, pero enfrenta un enemigo silencioso: las ocratoxinas, toxinas cancerígenas producidas por hongos como Penicillium y Aspergillus. Si las pasas superan los 10 microgramos por kilo permitidos, las pérdidas son totales.
Biotecnología al rescate
María Cristina Nally, investigadora del CONICET y directora del proyecto en el Instituto de Biotecnología (IBT) de la UNSJ, lidera el equipo que identificó levaduras nativas que frenan el crecimiento de hongos tóxicos.
Se trata de un método probado en cultivos como pistacho, cebolla y uva fresca. Ahora, están testeando estas levaduras en pasas sanjuaninas con ensayos in vitro e in vivo. “Queremos un biofungicida que reemplace a los químicos caros y riesgosos”, explica Nally.
A diferencia de los fungicidas tradicionales, que afectan la salud y el ambiente, este bioinsumo promete pasas más seguras y sostenibles, fortaleciendo la economía regional.
Un proyecto con sello internacional
Financiado por el Fondo Fiduciario Pérez Guerrero de Naciones Unidas, este esfuerzo reúne a científicos de Argentina, Chile, Uruguay, Brasil y México.
En San Juan, Nally trabaja con Virginia Pesce (codirectora), Fabio Vazquez y un equipo del IBT, mientras Julián Dib (PROIMI-CONICET) y Enzo Allori (UNT) suman expertise nacional. “Estamos emocionados, siempre buscamos fondos para innovar”, celebra Nally.
Impacto real: menos pérdidas, más exportaciones
Con Brasil y EE.UU. exigiendo estándares estrictos, este bioinsumo podría reducir rechazos y aumentar la cantidad exportable.
En un 2024, donde San Juan ya marcó récords, el proyecto apunta a largo plazo: pasas más saludables, menos costos para productores y un impulso a la economía cuyana. ¿El resultado? Un fruto seco argentino con buen sabor y beneficios para la salud.
En esta nota